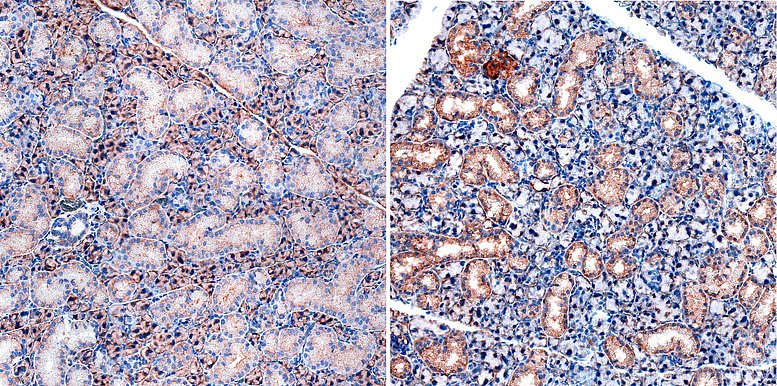

Neutrophil biology and immune regulation
Source: Uni-Klinikum Erlangen
Head: PD Dr. rer. nat Dr. habil. med. Luis E. Munoz
Neutrophils are the most abundant immune cell type and are equipped with several immunoregulatory tools. They patrol organs, migrate into injured tissues, and influence subsequent inflammatory responses. Neutrophils eject DNA-protein lattices known as neutrophil extracellular traps (NETs), which are endowed with intrinsic biological and mechanical properties that influence the tissue microenvironment and modulate the course of immune responses.
- The role of extracellular DNA traps during the development of sialadenitis and prmary Sjögren's syndrome (pSS).
Neutrophil migration and NET formation are fine-tuned by the autonomic nervous system, in particular by beta-adrenergic receptors. The role of NETs in the development of primary lesions on salivary epithelial cells and their contribution to the establishment of tertiary lymphoid organs and the pSS will be elucidated in this project.
- The effects of systemic immunosuppression on oral innate immunity.
The effects of systemic immunosuppression on cellular and humoral innate immunity and on the oral microbiome are being studied in collaboration with the Department of Oral and Maxillofacial Surgery.
| Luis E. Munoz Becerra | Research Group leader | |
| Marco Munoz Becerra | Data analyst | |
| Peter Scheuerlein | Technician | |
| Silke Winkler | Technician | |
| Martina Cobas Andrade | Scientific doctoral candidate | |
| Zhouqi Cheng | Scientific doctoral candidate | |
| Jule Schäfer | Scientific doctoral candidate | |
| Arpi Chobanian | Master student |
Deutsche Forschungsgemeinschaft (DFG)
Single application "The role of extracellular DNA traps in the development of sialadenitis and primary Sjögren´s Syndrome" (2022-2025)
European Commission
ERC RISE Grant "PANG - Pathogen and Graphene": Exploring the utility of novel graphene-based nanocomposites for the treatment of microbial infections. (2016-2019)
Federal Ministry for Economic Affairs and Climate Action (BMWi)
"Development of an adsorber to remove microaggregates from the blood of patients with sepsis." (2016-2017)
Ardea Biosciences Inc.
"Intravascular MSU Crystallization and its Biological Consequences." (2015-2018)
Fritz Thyssen Stiftung
"The role of IgG with different glycosylation type in the pathogenicity of immune complex formation in patients with rheumatologic diseases." (2014-2015)
IZKF, Universitätsklinikum Erlangen
A41 - "The molecular mechanism of the inflammatory cascade in crystal arthropathies." (2011-2013)
ELAN-Programm, Friedrich-Alexander-Universität Erlangen-Nürnberg
"Analysis of the phagocytotic synapse involved in the clearance of apoptotic cells." (2009-2010)
- Podolska MJ, Shan X, Janko C, Boukherroub R, Gaipl US, Szunerits S, Frey B, Muñoz LE. (2021) Graphene-Induced Hyperthermia (GIHT) combined with radiotherapy fosters immunogenic cell death. Front Oncol. 11:664615.
- Mahajan A, Hasíková L, Hampel U, Grüneboom A, Shan X, Herrmann I, Garreis F, Bock F, Knopf J, Singh J, Schauer C, Mahajan S, Leppkes M, Paulsen F, Schlötzer-Schrehardt U, Krenn V, Jünemann A, Hohberger B, Schett G, Herrmann M, Muñoz LE. (2021) Aggregated neutrophil extracellular traps occlude Meibomian glands during ocular surface inflammation. Ocul Surf. 20:1-12.
- Muñoz LE, Boeltz S, Bilyy R, Schauer C, Mahajan A, Widulin N, Grüneboom A, Herrmann I, Boada E, Rauh M, Krenn V, Biermann MHC, Podolska MJ, Hahn J, Knopf J, Maueröder C, Paryzhak S, Dumych T, Zhao Y, Neurath MF, Hoffmann MH, Fuchs TA, Leppkes M, Schett G, Herrmann M. (2019) Neutrophil Extracellular Traps Initiate Gallstone Formation. Immunity. 51(3):443-450.e4.
- Knopf J, Leppkes M, Schett G, Herrmann M, Muñoz LE. (2019) Aggregated NETs Sequester and Detoxify Extracellular Histones. Front Immunol. 10:2176.
- Mahajan A, Grüneboom A, Petru L, Podolska MJ, Kling L, Maueröder C, Dahms F, Christiansen S, Günter L, Krenn V, Jünemann A, Bock F, Schauer C, Schett G, Hohberger B, Herrmann M, Muñoz LE. (2019) Frontline Science: Aggregated neutrophil extracellular traps prevent inflammation on the neutrophil-rich ocular surface. J Leukoc Biol. 105(6):1087-1098.
- Biermann MH, Podolska MJ, Knopf J, Reinwald C, Weidner D, Maueröder C, Hahn J, Kienhöfer D, Barras A, Boukherroub R, Szunerits S, Bilyy R, Hoffmann M, Zhao Y, Schett G, Herrmann M, Munoz LE. (2016) Oxidative Burst-Dependent NETosis Is Implicated in the Resolution of Necrosis-Associated Sterile Inflammation. Front Immunol. 7:557.
- Muñoz LE, Bilyy R, Biermann MH, Kienhöfer D, Maueröder C, Hahn J, Brauner JM, Weidner D, Chen J, Scharin-Mehlmann M, Janko C, Friedrich RP, Mielenz D, Dumych T, Lootsik MD, Schauer C, Schett G, Hoffmann M, Zhao Y, Herrmann M. (2016) Nanoparticles size-dependently initiate self-limiting NETosis-driven inflammation. Proc Natl Acad Sci U S A. 113(40):E5856-E5865.
- Maueröder C, Chaurio RA, Dumych T, Podolska M, Lootsik MD, Culemann S, Friedrich RP, Bilyy R, Alexiou C, Schett G, Berens C, Herrmann M, Munoz LE. (2016) A blast without power - cell death induced by the tuberculosis-necrotizing toxin fails to elicit adequate immune responses. Cell Death Differ. 23(6):1016-25.
- Leppkes M, Maueröder C, Hirth S, Nowecki S, Günther C, Billmeier U, Paulus S, Biermann M, Munoz LE, Hoffmann M, Wildner D, Croxford AL, Waisman A, Mowen K, Jenne DE, Krenn V, Mayerle J, Lerch MM, Schett G, Wirtz S, Neurath MF, Herrmann M, Becker C. (2016) Externalized decondensed neutrophil chromatin occludes pancreatic ducts and drives pancreatitis. Nat Commun. 7:10973.
- Schauer C, Janko C, Munoz LE, Zhao Y, Kienhöfer D, Frey B, Lell M, Manger B, Rech J, Naschberger E, Holmdahl R, Krenn V, Harrer T, Jeremic I, Bilyy R, Schett G, Hoffmann M, Herrmann M. (2014) Aggregated neutrophil extracellular traps limit inflammation by degrading cytokines and chemokines. Nat Med. 20(5):511-7.
PubMed Publication list of PD Dr. Dr. Luis E Munoz